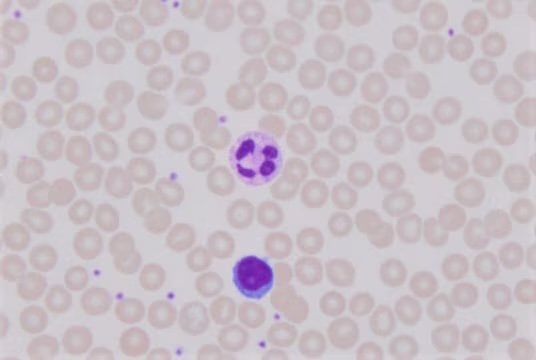
کنترل کیفی رنگ گیمسا

کنترل کیفی رنگ گیمسا (Giemsa Stain): روش انجام، ارزیابی کیفیت و نکات مهم آزمایشگاهی
کنترل کیفی رنگ گیمسا شامل پایش منظم pH بافر (۶.۸ برای گسترش خون محیطی و ۷.۲ برای انگلها)، بررسی ظاهری و نگهداری صحیح رنگ، استفاده از لام کنترل، ارزیابی زمان و دمای رنگآمیزی، فیلتر دورهای رنگ و مستندسازی کامل است تا وضوح هسته، تعادل رنگی RBC/WBC و شفافیت پسزمینه تضمین شود.
جهت عضویت در کانال آموزشی در تلگرام به لینک زیر مراجعه کنید:
https://t.me/hematology_education
فهرست مطالب
مقدمه در مورد کنترل کیفی رنگ گیمسا
رنگ گیمسا یکی از پرکاربردترین رنگها در آزمایشگاههای هماتولوژی، انگلشناسی و سیتولوژی است. این رنگ برای مشاهدهی گسترش خون محیطی، مغز استخوان، و انگلهایی مثل پلاسمودیوم (عامل مالاریا) استفاده میشود. از آنجا که ظاهر سلولها و انگلها بهشدت تحت تأثیر کیفیت رنگ و شرایط رنگآمیزی است، انجام کنترل کیفی منظم رنگ گیمسا برای اطمینان از دقت نتایج ضروری است.
جهت مطالعه ی جامع در مورد آزمایش های پایه ای خون و مغز استخوان به لینک زیر مراجعه کنید:
دوره جامع آموزش تصویری هماتولوژی – فصل پنج: آزمایش های پایهای خون و مغز استخوان
🎯 اهداف کنترل کیفی رنگ گیمسا
- اطمینان از ثبات رنگپذیری سلولها در تمام نمونهها
- تشخیص بهموقع تغییر رنگ، رسوب یا آلودگی در محلول
- حفظ یکنواختی رنگ بین لامهای مختلف
- جلوگیری از تفسیر اشتباه در بررسیهای میکروسکوپی
⚗️ ترکیب و اصول عملکرد رنگ گیمسا
رنگ گیمسا از ترکیب آزور II، متیلن بلو و ائوزین Y تشکیل شده است. این ترکیب قادر است اجزای بازی سلول (مانند هسته) را بنفش و اجزای اسیدی (مانند سیتوپلاسم) را صورتی نشان دهد. در نتیجه، تعادل بین رنگهای اسیدی و بازی کاملاً به pH محلول بافر رنگآمیزی وابسته است.
💧 اهمیت pH در رنگآمیزی گیمسا
چرا pH مهم است؟ (کنترل pH رنگ گیمسا)
pH محیط رنگآمیزی تعیینکنندهی شدت جذب رنگ توسط اجزای سلولی است. کوچکترین تغییر در pH باعث تغییر در ظاهر نهایی لام میشود و میتواند تفسیر نتایج را تحتتأثیر قرار دهد.
🔬 pH مناسب رنگ گیمسا چقدر است؟ (۶.۸ در برابر ۷.۲)
در منابع علمی دو عدد مختلف برای pH توصیه شده است: ۶.۸ و ۷.۲. این اختلاف به دلیل نوع کاربرد رنگ گیمسا و هدف رنگآمیزی است.
| نوع کاربرد | pH توصیهشده | توضیح |
|---|---|---|
| گسترش خون محیطی و مغز استخوان | ۶.۸ ± ۰.۰۵ | بهترین تعادل بین رنگ RBC و هسته سلول |
| رنگآمیزی انگلها (مثل مالاریا) | ۷.۲ ± ۰.۰۵ | وضوح بالاتر کروماتین و سیتوپلاسم انگل |
| رنگآمیزی سیتوژنتیک | ۷.۰ تا ۷.۲ | تفکیک واضحتر باندهای کروموزومی |
⚖️ تأثیر pH بر نتیجه رنگآمیزی
| مقدار pH | اثر بر گلبول قرمز | اثر بر هسته سلول | تفسیر |
|---|---|---|---|
| < 6.8 | بیش از حد قرمز | کمرنگ و مبهم | محیط اسیدی |
| 6.8–7.0 | طبیعی و واضح | بنفش تیره | ایدهآل برای CBC |
| 7.2–7.4 | مایل به آبی | بسیار پررنگ | مناسب برای انگلشناسی |
🧩 نتیجهگیری دربارهی pH در کنترل کیفی رنگ گیمسا
نکته مهم: عدد pH بههیچوجه ثابت و واحد نیست.
اگر رنگ گیمسا برای گسترش خون محیطی استفاده میشود، pH = 6.8 بهترین گزینه است. اما برای رنگآمیزی انگلها یا کارهای سیتوژنتیک، pH = 7.2 نتایج واضحتری از ساختار هستهای و جزئیات انگل ارائه میدهد. در هر صورت، ثبات pH در طول زمان از هر عدد خاصی مهمتر است.
🧫 مراحل کنترل کیفی رنگ گیمسا
۱) بررسی ظاهری رنگ (شفافیت، تغییر رنگ، رسوب)
رنگ باید بنفش مایل به آبی و شفاف باشد. در صورت کدورت یا تهنشینی، نشانه فساد یا آلودگی است.
۲) بررسی تاریخ و نگهداری (شرایط دما و نور)
در ظروف تیره و در دمای ۴ تا ۸ درجه سانتیگراد نگهداری شود. درب ظرف همیشه محکم بسته شود تا از تبخیر متانول جلوگیری گردد.
۳) کنترل با نمونه شاهد (لام کنترل)
یک لام از خون سالم با رنگ گیمسای تأییدشده تهیه و نگهداری شود. در هر نوبت رنگآمیزی، لام جدید با آن مقایسه شود تا هرگونه تغییر رنگ مشخص گردد.
نتیجه مطلوب در لام کنترل: سیتوپلاسم لنفوسیت: آبی روشن؛ هسته لنفوسیت: بنفش تیره؛ سیتوپلاسم نوتروفیل: صورتی مایل به بنفش؛ گرانولهای ائوزینوفیل: نارنجی قرمز؛ گرانولهای بازوفیل: آبی تیره.
۴) کنترل pH بافر رنگآمیزی (۶.۸ و ۷.۲)
بافر باید pH ۶.۸ ± ۰.۰۵ برای آزمایشهای خونی و ۷.۲ ± ۰.۰۵ برای انگلشناسی داشته باشد. اندازهگیری با pH متر یا کاغذ اندیکاتور انجام شود. در صورت انحراف از محدوده، بافر جدید تهیه گردد.
۵) کنترل زمان و دمای رنگآمیزی (۱۵–۲۰ دقیقه؛ ۲۲–۲۵°C)
زمان مناسب: ۱۵ تا ۲۰ دقیقه در دمای ۲۲ تا ۲۵ درجه سانتیگراد. زمان کمتر → رنگپریدگی؛ زمان بیشتر → پسزمینه آبی یا رسوب رنگ.
۶) کنترل آلودگی میکروبی و فیلتر دورهای
در صورت نگهداری طولانیمدت، رشد باکتری میتواند باعث تغییر رنگ و بوی نامطبوع شود. برای پیشگیری، هر چند ماه یکبار رنگ را از فیلتر ۰.۴۵ میکرون عبور دهید.
🧩 کنترل کیفی دورهای (روزانه، هفتگی، ماهانه)
| تناوب | نوع کنترل | هدف |
|---|---|---|
| روزانه | بررسی لام کنترل | کنترل رنگآمیزی روزانه |
| هفتگی | بررسی ظاهر و pH رنگ | تشخیص تغییر جزئی کیفیت |
| ماهانه | فیلتر رنگ و تهیه بافر تازه | پیشگیری از آلودگی |
⚠️ نکات مهم در کنترل کیفی رنگ گیمسا
- پیش از استفاده، بطری رنگ را به آرامی هم بزنید تا تهنشینی یکنواخت شود.
- از تماس رنگ با نور مستقیم یا گرما خودداری کنید.
- برای هر نوبت رنگآمیزی از آب مقطر تازه و بافر استاندارد استفاده شود.
- لامها را بعد از رنگآمیزی با آب بافر شستوشو دهید نه آب معمولی.
- هر تغییر غیرعادی در رنگ سلولها باید بهصورت کتبی در فرم کنترل کیفی ثبت شود.
🧾 مستندسازی (فرم کنترل رنگها) کنترل کیفی رنگ گیمسا
نتایج کنترل کیفی باید در فرم کنترل رنگها ثبت شوند و شامل موارد زیر باشند: تاریخ آمادهسازی رنگ، pH و زمان رنگآمیزی، نتیجه مقایسه با لام کنترل، امضای مسئول کنترل کیفی. این مستندات در بازرسیهای آزمایشگاهی (مثل ISO 15189) ضروریاند.
سوالات رایج در مورد کنترل کیفی رنگ گیمسا
1) چرا بعضی منابع pH=7.2 و برخی 6.8 را پیشنهاد میکنند؟
به دلیل تفاوت کاربرد: ۶.۸ برای گسترش خون محیطی، ۷.۲ برای انگلشناسی و برخی کاربردهای سیتوژنتیک.
2) اگر pH از ۶.۸ پایینتر باشد چه میشود؟
RBC بیشازحد قرمز و هستهها کمرنگ دیده میشوند؛ نتیجه به سمت رنگآمیزی اسیدی میرود.
3) اگر pH به ۷.۲–۷.۴ برسد چه اثری دارد؟
RBC کمی مایل به آبی و هستهها پررنگتر میشوند؛ برای انگلشناسی مفید است.
4) زمان بهینه رنگآمیزی گیمسا چقدر است؟
۱۵ تا ۲۰ دقیقه در دمای اتاق (۲۲–۲۵°C)؛ کمتر از آن رنگپریدگی و بیشتر از آن پسزمینه آبی ایجاد میکند.
5) بهترین روش نگهداری رنگ گیمسا چیست؟
در ظروف تیره، ۴–۸°C، دور از نور و با درب محکم برای جلوگیری از تبخیر متانول.
6) نشانههای افت کیفیت رنگ چیست؟
کدورت، رسوب، تغییر رنگ به قهوهای، بوی غیرطبیعی، پسزمینه آبی پایدار روی لام.
7) چرا لام کنترل ضروری است؟
برای مقایسه یکنواختی عملکرد رنگ در نوبتهای مختلف و تشخیص سریع تغییرات.
8) فیلتر کردن رنگ هر چند وقت انجام شود؟
تقریباً هر ۲–۳ ماه یکبار یا هر زمان رسوب مشاهده شد؛ با فیلتر ۰.۴۵ µm.
9) اگر پسزمینه لام آبی شد چه کاری انجام دهم؟
غلظت رنگ، زمان رنگآمیزی و شستوشو را بازبینی کنید؛ از آب بافر استاندارد استفاده کنید.
10) pH بافر را با چه ابزاری بسنجیم؟
pH متر کالیبرهشده (ترجیحاً) یا کاغذ اندیکاتور با دقت بالا؛ در صورت انحراف، بافر تازه تهیه شود.
منابع معتبر (WHO و NIH)
